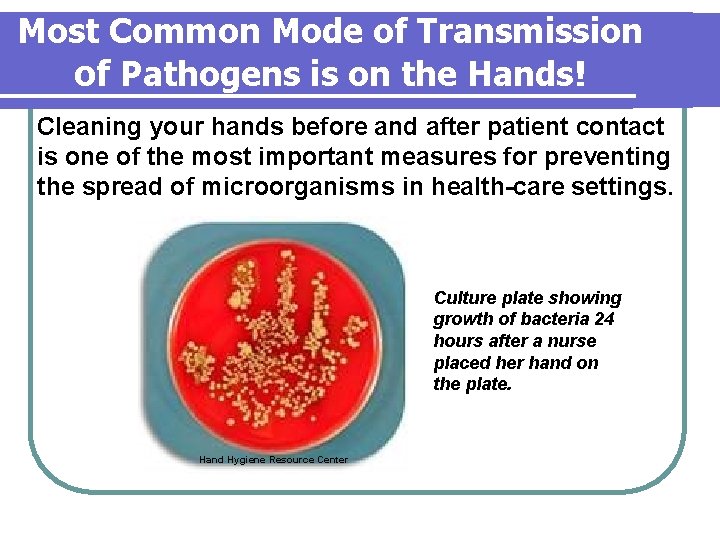
Most Common Mode of Transmission of Pathogens is on the Hands! Cleaning your hands Most Common Mode of Transmission of Pathogens is on the Hands! Cleaning your hands

Hand Hygiene in Dental HealthCare Settings 112006 Definitions

- Slides: 55
Hand Hygiene in Dental Health-Care Settings 11/2006
Definitions l Handwashing l washing hands with plain (nonantimicrobial) soap and water l Antiseptic Handwashing hands with water & soap or other detergents containing an antiseptic agent l
Definitions l Alcohol-Based Hand Rub l l alcohol-containing preparations (usually contain 60%– 95% ethanol or isopropanol) applied to the hands to reduce the number of viable microorganisms waterless antiseptic agents not requiring the use of exogenous water
Definitions l Surgical Hand Hygiene/Antisepsis l l antiseptic handwash or antiseptic hand rub performed before a surgical procedure by personnel to eliminate transient and reduce resident hand flora antiseptic detergent preparations often have persistent antimicrobial activity
Definitions l Hand l Hygiene general term that applies to handwashing, antiseptic handwash, antiseptic hand rub, or surgical hand antisepsis
Definitions l Oral Surgical Procedure involves the incision, excision, or reflection of tissue that exposes normally sterile areas of the oral cavity l examples include biopsy, periodontal surgery, apical surgery, implant surgery, and surgical extractions of teeth (e. g. , removal of erupted or nonerupted tooth requiring elevation of mucoperiosteal flap, removal of bone or sectioning of tooth, and suturing if needed) l
Definitions l Transient Flora (“contaminating flora”) colonize superficial layers of skin l more easily removed by routine handwashing l acquired by health-care personnel (HCP) during direct contact with patients or contaminated environmental surfaces l Source: CDC
Definitions l Resident Flora (“colonizing flora”) attached to deeper layers of skin l more resistant to removal l less likely to be associated with infections l Source: CDC
Most Common Mode of Transmission of Pathogens is on the Hands! Cleaning your hands before and after patient contact is one of the most important measures for preventing the spread of microorganisms in health-care settings. Culture plate showing growth of bacteria 24 hours after a nurse placed her hand on the plate. Hand Hygiene Resource Center
Track Record on Handwashing in Health-Care Facilities l Although handwashing has been proven to reduce the spread of germs in health-care facilities, HCP do not wash their hands when recommended. l Workers only wash their hands approximately 40% of the time. Guideline for Hand Hygiene in Health-Care Settings MMWR, vol. 51, no. RR-16.
Track Record on Handwashing in Health-Care Facilities 1. Gould D, J Hosp Infect 1994; 28: 15 -30. 2. Larson, J Hosp Infect 1995; 30: 88 -106. 3. Slaughter S, Ann Intern Med 1996; 3: 360 -365 4. Watanakunakorn C, Infect Control Hosp Epidemiol 1998; 19: 858 -860 5. Pittet D, Lancet 2000: 356: 1307 -1312
Self-Reported Reasons for Poor Compliance Handwashing agents cause skin irritation & dryness (via frequent use of soap & water) l Sinks are inconveniently located/lack of sinks l l l Lack of soap & paper towels Too busy/handwashing takes too long Wearing of gloves Hands don’t look dirty Low risk of acquiring infection from patients Adopted from Pittet, D. Infection Control and Hospital Epidemiology 2000; 21: 381 -386.
handwashing! ≠
Wearing gloves does not replace the need for hand hygiene Small, inapparent defects l Frequently torn during use l Hands frequently become contaminated during removal l De. Groot-Kosolcharoen 1989, Korniewicz 1989, Kotilainen 1989, Olsen 1993, Larson 1995, Murray 2001, Burke 1996, Burke 1990, Nikawa 1994, Nikawa 1996, Otis 1989
Specific Indications for Hand Hygiene Before and after treating each patient (e. g. , before glove placement and after glove removal) l After barehanded touching of inanimate objects likely to be contaminated by blood or saliva l Before regloving after removing gloves that are torn, cut, or punctured l Before leaving the dental operatory l
Which method do you use to clean your hands at work? 1. Plain soap and water 2. Antimicrobial soap and water 3. Alcohol-based hand rub
Techniques and Tips……
How to Wash Your Hands Using plain or antimicrobial soap l Wet hands and wrists under cool running water (avoid hot water). l Dispense handwashing agent sufficient to cover hands and wrists—about 3– 5 m. L. l Rub the agent into all areas for at least 15 seconds, with particular emphasis around nails and between fingers, before rinsing with cool water.
How to Wash Your Hands Using plain or antimicrobial soap l Dry hands completely with disposable towels before donning gloves. l Use a towel to turn off the faucet if automatic controls are not available.
Handwashing Tips
Handwashing Tips Drying Your Hands Aids the removal of soil, loose skin, and microorganisms. l Remaining moisture can enhance the pick up and deposition of any remaining microorganisms. l Preventing hand contamination at any time during the whole process is key. l
How to Use an Alcohol-Based Hand Rub l Do not use if hands are visibly soiled. l Apply 1. 5 to 3 m. L of an alcohol gel or rinse to the palm of one hand, and rub hands together (volume– based on manufacturer). l Cover all surfaces of your hands and fingers, including areas around/under fingernails.
How to Use an Alcohol-Based Hand Rub l Continue rubbing hands together until alcohol has dried. l If you applied a sufficient amount of alcohol-based hand rub, it should take at least 10 – 15 seconds of rubbing before your hands feel dry.
Alcohol-Based Hand Rub Tips l If you feel a “build-up” of emollients on your hands after cleaning your hands 5 to 10 times with an alcoholbased hand rub, wash your hands with soap and water. l Ensure the alcohol-based hand rub has completely dried before putting on gloves.
If hands are NOT visibly soiled: non-antimicrobial or antimicrobial soap & water (minimum of 15 seconds) or alcohol-based hand rub (apply & rub hands until dry)
Surgical Hand Hygiene/Antisepsis Technique Remove rings, watches, and bracelets. l Remove debris from underneath fingernails using a nail cleaner under running water. l Wet hands and wrists under cool running water. l
Surgical Hand Hygiene/Antisepsis Technique Using an antimicrobial agent, scrub hands and forearms for the length of time recommended by the manufacturer’s instructions (usually 2 to 6 minutes) before rinsing with cool water. l Dry hands completely (using a sterile towel is ideal) before donning sterile surgeon’s gloves. l
Surgical Hand Hygiene/Antisepsis Using an Alcohol-Based Hand Rub l Follow manufacturer recommendations l Before applying the alcohol based surgical hand-scrub product with persistent activity, pre-wash hands and forearms with nonantimicrobial soap and water. Guideline for Hand Hygiene in Health-Care Settings. MMWR 2002; vol. 51, no. RR-16.
Alcohol-Based Hand Rubs l Alcohol-based hand rubs are an option to traditional handwashing, primarily to increase compliance.
If hands are NOT visibly soiled: non-antimicrobial or antimicrobial soap & water (minimum of 15 seconds) or alcohol-based hand rub (apply & rub hands until dry)
Alcohol-Based Preparations Benefits Rapid and effective antimicrobial action l Reduced time for hand disinfection l Improved skin condition l More accessible than sinks-potential to increase compliance l Limitations Cannot be used if hands are visibly soiled l Follow instructions for amount to “rub” l Flammableimplement safety precautions l “Build-up” l
Efficacy of Hand Hygiene Preparations in Killing Bacteria Good Plain soap Better Best Antimicrobial Alcohol-based hand rub soap Guideline for Hand Hygiene in Health-Care Settings MMWR, vol. 51, no. RR-16.
Ability to Kill Bacteria on Hands % log Time after disinfection 0 60 180 minutes Bacterial Reduction 99. 9 3. 0 99. 0 2. 0 Alcohol handrub (70% Isopropanol) 90. 0 1. 0 Antimicrobial soap (4% Chlorhexidine) 0. 0 Baseline Plain soap Adapted from: Hospital Epidemiology and Infection Control, 2 nd Edition, 1999.
Effect of Alcohol Hand Rub on Skin Condition Self-reported skin score Epidermal water content Dry Healthy Dry ~ Alcohol-based hand rub is less damaging to the skin ~ Boyce, Infection Control and Hospital Epidemiology 2000; 21: 438 -41.
Using an Alcohol-Based Hand Rub Takes Less Time To correctly wash your hands it can take approximately 1– 2 minutes. l HCP can effectively decontaminate their hands using an alcohol-based hand rub in 18– 27 seconds. l Guideline for Hand Hygiene in Health-Care Settings MMWR, vol. 51, no. RR-16.
Alcohols and Flammability Alcohols are flammable l Alcohol-based hand rubs should be stored away from high temperatures or flames and electrical outlets. l Restrictions on the amount of product in operatories l l Consider using smaller pump dispensers vs. wall-mounted dispensing systems - Guideline for Hand Hygiene in Health-care Settings MMWR, vol. 51, no. RR-16. - National Fire Protection Association (NFPA) published amended guidance to the Life Safety Code (LSC)
Do Not Place Alcohol Hand-Rub Dispensers Adjacent to Sinks l May cause personnel to routinely wash their hands with soap and water after each use of an alcohol hand rub not necessary l not recommended l may lead to dermatitis l Guideline for Hand Hygiene in Health-Care Settings MMWR, vol. 51, no. RR-16.
Alcohol-Based Hand Rubs & Dentistry l May be most useful l Exam rooms l Radiology l Dental residencies l Deployments
Hand Hygiene Agents: Factors to Consider l Efficacy of agent against various pathogens l Acceptance of product by health-care personnel Characteristics of product l Skin irritation & dryness l l Accessibility of product l Dispenser systems Guideline for Hand Hygiene in Health-care Settings MMWR, vol. 51, no. RR-16.
Skin Care: Moisturizers & Lotions l Healthy, unbroken skin is the primary defense against infection and transmission of pathogens. l Provide HCP with hand lotions or creams to help ease the dryness from frequent handwashing and to prevent dermatitis from glove use.
Skin Care: Moisturizers & Lotions l Obtain information from manufacturers regarding effects hand lotions, creams, or alcohol-based hand rubs may have on antimicrobial soaps or gloves. Guideline for Hand Hygiene in Health-Care Settings MMWR, vol. 51, no. RR-16.
Skin Care: Moisturizers & Lotions ONLY USE MTF-approved and supplied lotions Because……. . l Some lotions may make medicated soaps less effective. l Some lotions cause breakdown of latex gloves—petroleumbased lotion formulations can weaken latex gloves and increase permeability. *MTF=Medical Treatment Facility
Skin Care: Moisturizers & Lotions l Soaps and lotions can become contaminated with bacteria if dispensers are refilled. l Do not add soap or lotion to a partially empty dispenser (i. e. , top off). l Use disposable closed containers or closed containers that can be washed and dried before refilling.
Fingernails & Artificial Nails l Keep fingernails short Allows thorough cleaning and prevents glove tears l Long nails make glove placement more difficult and may result in glove perforation l
Fingernails & Artificial Nails l Follow MTF policy regarding artificial fingernails; use of artificial fingernails is usually not recommended. USAF Guidelines for Infection Control in Dentistry, 2004.
Fingernails, Nail Polish, Jewelry l Chipped nail polish can harbor bacteria; unchipped nail polish on short natural nails is acceptable. l Do not wear hand or nail jewelry if it makes donning gloves more difficult or compromises the fit and integrity of the glove. USAF Guidelines for Infection Control in Dentistry, 2004.
% recovery of gram negative bacteria Can a Fashion Statement Harm the Patient? ARTIFICIAL POLISHED NATURAL P < 0. 05 Avoid wearing artificial nails; keep natural nails short (<1/4 inch) Edel et. al, Nursing Research 1998: 47; 54 -59
Education/Motivation Programs Make improved hand hygiene a priority. l Monitor HCP adherence with recommended hand-hygiene practices and provide feedback. l Implement a multidisciplinary program to improve adherence to recommended practices. l Hand Hygiene is the single most important means of preventing infections. Guideline for Hand Hygiene in Health-Care Settings MMWR, vol. 51, no. RR-16.
Before introducing new hand-hygiene products into your practice: l Carefully evaluate your current hand hygiene practices and compliance. l Consider the relative efficacy of antiseptic agents against various pathogens.
Before introducing new hand-hygiene products into your practice: Solicit input from the staff regarding the feel, fragrance, and skin tolerance of any products under consideration. l Evaluate dispenser systems to ensure that dispensers function adequately and deliver an appropriate volume of product. l
Before introducing new hand-hygiene products into your practice: l Solicit information from manufacturers regarding any known interactions between products used to clean hands, skin care products, and the types of gloves used in your practice.
Summary Routine Hand Hygiene Choices Soap & Water Hands visibly soiled with blood or proteinaceous material Hands not visibly soiled Antimicrobial Soap & Water Alcohol. Based Hand Rub
Summary Surgical Hand Hygiene Choices Soap & Water Antimicrobial Soap* & Water Soap & Water Followed by Alcohol. Based Hand Rub* Surgical Hand Antisepsis * Persistent effect, broad spectrum of activity, fast-acting
Hand hygiene is the single most important infection control measure.
References CDC. Guideline for hand hygiene in health-care settings: recommendations of the Healthcare Infection Control Practices Advisory Committee and the HICPAC/SHEA/APIC/IDSA Hand Hygiene Task Force. MMWR 2002; 51(No. RR-16). l CDC. Guidelines for infection control in dental health-care settings – 2003. MMWR 2003; 52(No. RR-17): 1– 66. l Hand Hygiene Resource Center: www. handhygiene. org. l USAF guidelines for infection control in dentistry, 2004. l